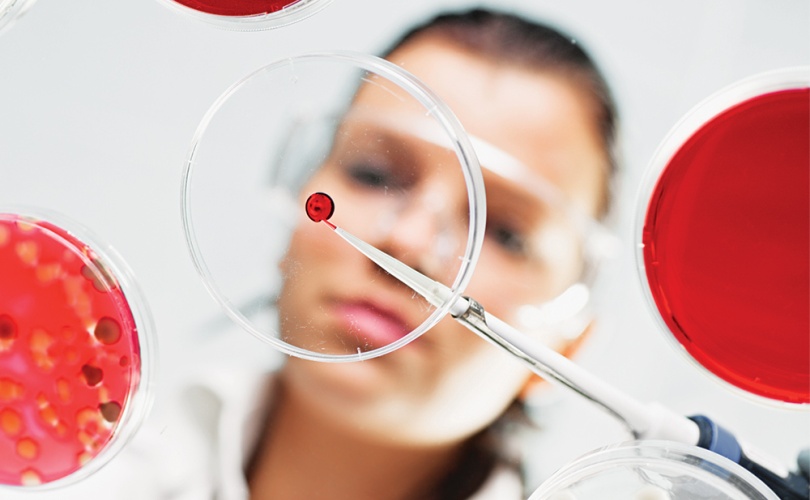
Researcher in a lab.

All the modern medical advances that we take for granted, from hip replacements to cardiac surgery, depend on one thing: the ability to control infectious diseases.
“The rise of superbugs and resistance to antibiotics is threatening this world,” explains Dr. Don Sheppard, Director of the McGill Interdisciplinary Initiative in Infection and Immunity (MI4).
“The vision for MI4 really came from trying to tackle this impending health crisis,” says Sheppard, who is also Chair of the Department of Microbiology and Immunology at McGill’s Faculty of Medicine.
MI4 was established in 2018 with an extraordinary $15-million gift from the Doggone Foundation to McGill’s Faculty of Medicine and the Research Institute of the McGill University Health Centre (RI-MUHC).
The unique initiative brings together more than 250 researchers and clinicians from McGill and its affiliated hospitals and research centres. Their patient-centred mission? To develop innovative solutions to infectious and immune threats.
MI4 powered up in 2019, awarding its first round of seed fund grants. The 12 grants of $150,000 support research in a range of areas, from Lyme disease and tuberculosis, to exploring new ways to boost our therapeutic arsenal against bacterial infections.

Curbing the spread of drug-resistant bacteria
With their seed grant, Dr. Dao Nguyen, MDCM’97, MSc’04, a scientist at the RI-MUHC, and Nathalie Tufenkji, BEng’00, a Canada Research Chair in the Department of Chemical Engineering, are using nature-inspired nanostructures to design antimicrobial biomaterials.
Their research revolves around the antibacterial properties of dragonfly and cicada wings, which are covered in tiny spikes that can kill bacteria upon contact.
Nguyen, a clinician-scientist specializing in biology, and Tufenkji, an engineer, have joined forces “to develop a brand-new way to coat materials that renders them completely resistant to infection, just the way that the dragonfly wing is resistant to infection,” explains Sheppard.
Their collaboration illustrates the unique interdisciplinary nature of MI4.
“Those two people would never meet and have a conversation if it wasn’t for the vehicle that MI4 is providing,” says Sheppard, who notes that complex problems require a team approach, creating links between people with different perspectives and skill sets.
Reducing immune side effects in cancer patients
With a research seed grant co-funded by the Goodman Cancer Research Centre (GCRC), scientists Dr. Inés Colmegna, from the RI-MUHC, and Dr. Logan Walsh from the GCRC, are investigating the best therapeutic approach for side effects in cancer patients being treated with immune checkpoint inhibitors.
These drugs have revolutionized oncology by activating the immune system to kill tumour cells. Yet many patients develop adverse reactions to the heightened immune activation, with up to half developing immune-related side effects. And recent evidence suggests that some immunosuppressive treatments used to control that damage may be associated with reduced patient survival.
Thanks to their seed grant, Drs. Colmegna and Walsh are empowered to define how best to minimize these negative outcomes.
Eradicating hepatitis C in Montreal
MI4 will also fund its flagship programs, which focus more on delivering solutions than inventing new ones, such as its hepatitis C program, Montréal sans HépC.
Treatment exists to cure this viral infection of the liver, but the populations that need the treatment most – refugees, Indigenous people, IV drug users and prisoners – aren’t well engaged with the health care system.
The program will work with partners in high-risk communities and aims to eradicate the virus from the island of Montreal – which would be a first for a major city in North America.
“We need creative solutions to deliver these drugs and testing strategies to that population in a way that makes sense to them,” says Sheppard. “It doesn’t make sense to say, ‘we’ll cure you if you come to the hospital’, if people don’t want to go there.”

